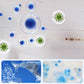
Mold mildew remover spray

Mold mildew remover spray
Mold mildew remover spray

Não foi possível carregar a disponibilidade de recolha

Still using old methods to brush away mold? Still fighting against the growing and new mold spots year after year? Introduce you the Mold mildew remover spray——A nice household gift for friend!




Mildew Removal Spray is the perfect solution for quickly and easily removing mildew stains from a variety of surfaces. This spray is designed to quickly remove stains without heavy scrubbing, making it easy to use and perfect for those hard to reach areas.


Disinfects and leaves refreshing fragrance
Simply spray the affected area, wait until the stain disappears, then rinse. The spray is safe to use on a variety of materials, including wood, vinyl, tile, and more.















EASY TO USE
Quickly removes stains caused by mold and mildew on contact without heavy scrubbing,spray, wait until the stain disappears, then rinse

Highly effective designed to clean mold and mildew on contact, without the need for heavy scrubbing. This spray is also designed to penetrate deep into surfaces, ensuring that all mold and mildew is removed.


Scope of application
Mainly used for removing mold on indoor and outdoor white walls and floors.
Restore the original color of the wall in 10 to 30 minutes without damaging it, and inhibit mold regeneration for a long time.

Usage:
1. Wear a mask and gloves, and shake the product evenly. Adjust the spray nozzle to the spray gear;
2. Evenly spray the mold remover at the mold prone position, with a distance of 20CM-30CM from the moldy surface of the wall.
3. The mold can be removed within about 30 minutes after spraying, making the wall surface intact and returning to its original color. The specific effective time depends on the environment. If there is a lot of mold, which cannot be completely removed or the clothing surface turns yellow, it can be sprayed repeatedly

EFFORTLESSLY REMOVE MOLD & MILDEW STAINS
Our premium mildew stain remover starts working on contact to break up and dissolve mildew and mold stains without harsh scrubbing. Won't damage stitching on seats, chairs, pillows, cushions or canopies.
SAFE FOR VARIOUS MATERIALS
On the boat, RV, or bathroom tile grout, shower walls, curtains & carpet. Safe on fiberglass, plastic, rubber, deck, wood, vinyl siding, pool & patio outdoor furniture, upholstery, canvas, bimini tops & life jackets.


PREVENTS MILDEW STAIN FORMATION
This fabric mold and mildew stain remover continues to control after applied to prevent mold & mildew stains. A fast and amazingly effective cleaner - simply spray on, allow black stains to disappear and rinse off!

Specification
Main ingredients: decomposition agents, oxidants, etc
For: Used to remove stubborn mold spots and common molds on walls, such as Aspergillus niger, Aspergillus flavus, and other high incidence molds.
Area: The construction area is about 10 square meters, depending on the actual moldy condition.


Note:
Please keep away from children
NOSSA GARANTIA
NOSSA GARANTIA